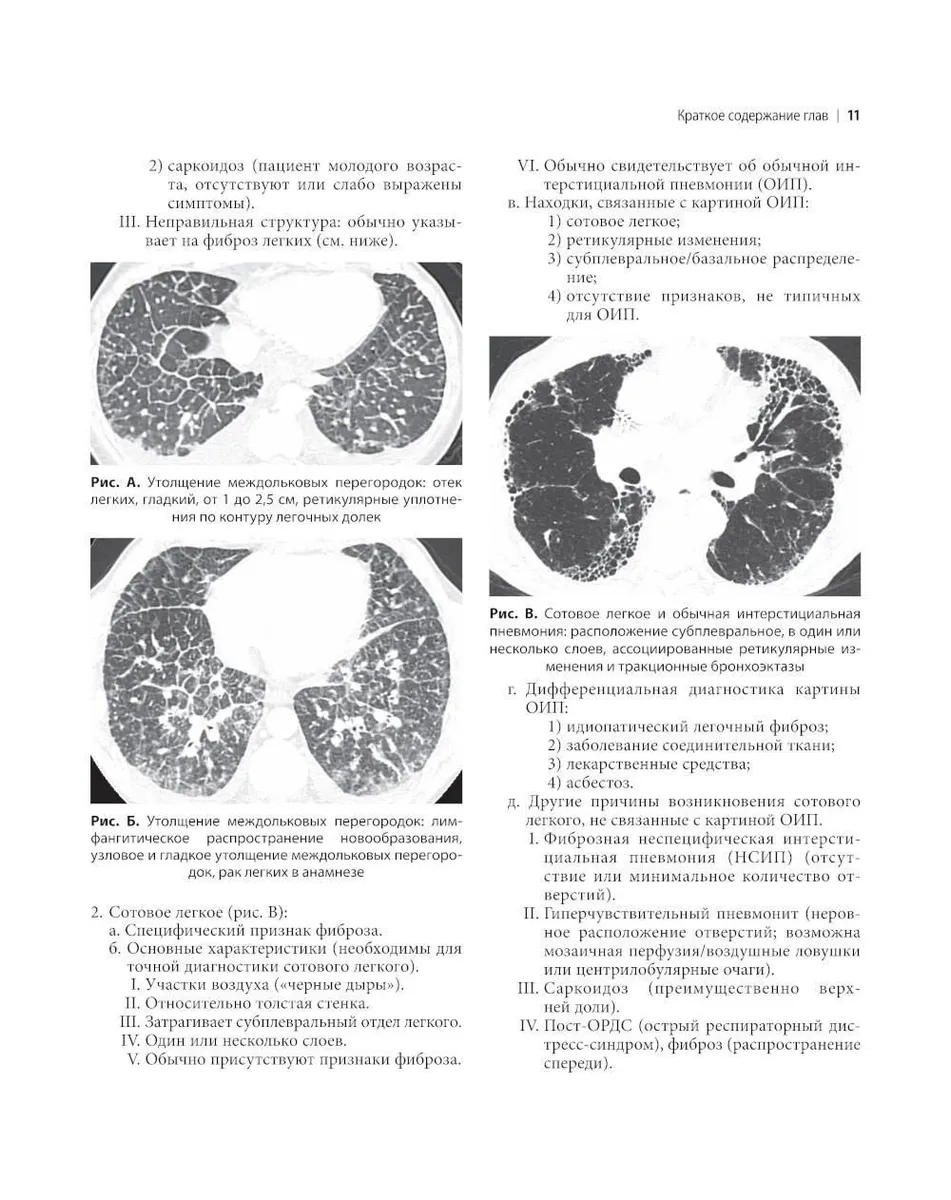

Утолщение интерстиция
Утолщение интерстиция 112 фото
Сайт архивы югры
Xiaomi redmi 8 pro процессор
Приставы нефтекамска номер телефона
Что должен знать мужчина о женщине
Ноутбук asus vivobook 16 m1605ya mb329
В чем суть любого конфликта
Расписание электричек савеловского вокзала 94
Поздравления с днем рождения всех благ
Смеситель для ванны grohe с длинным
Мужеложство в исламе
Сайт 8 нижневартовск
Косвенный налог это простыми словами
Nasd 6.24
Сайт российского ипподрома
Магнитные бури в феврале 2025 года сегодня
Архипелаг острых гор
Цвет платья и кроссовок
Химки 11 почта
Социальная пенсия по инвалидности индексация в 2025
Читать академия отверженных